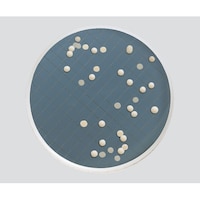
�l���������@�~���t���b�N�X�v���X�p�|�n�@�T�u���[�u�h�E�����V�|�n�@�l�w�r�l�b�r�c�S�W�@�P��

第19位
森永製菓 inゼリー エネルギーブドウ糖 180g x6 4902888728808 栄養補助食品 1セット(180gx6)
いつでもどこでも、素早く飲むことができる、ブドウ糖が手軽に摂れるゼリー飲料。ラムネ味。
いつでもどこでも、素早く飲むことができる、ブドウ糖が手軽に摂れるゼリー飲料。ラムネ味。+もっと見る
秋山産業 秋山 高麗人参茶3g×30包 4963856222582 栄養補助食品 1個
高麗人参の根の部分から取ったエキスにブドウ糖を加え、どなたにも飲みやすいように顆粒状に仕上げました。
高麗人参の根の部分から取ったエキスにブドウ糖を加え、どなたにも飲みやすいように顆粒状に仕上げました。+もっと見る
ポッカサッポロ キレートレモン クエン酸2700ゼ x6個
レモン1個分の果汁、1日分のビタミンC、すばやくエネルギーになるブドウ糖、継続的な飲用で日常生活や運動後の疲労感を軽減するクエン酸(機能性関与成分)が2700mg入った機能性表示食品のレモンゼリー
レモン1個分の果汁、1日分のビタミンC、すばやくエネルギーになるブドウ糖、継続的な飲用で日常生活や運動後の疲労感を軽減するクエン酸(機能性関与成分)が2700mg入った機能性表示食品のレモンゼリー+もっと見る
9件中1~9件を表示中
- 1